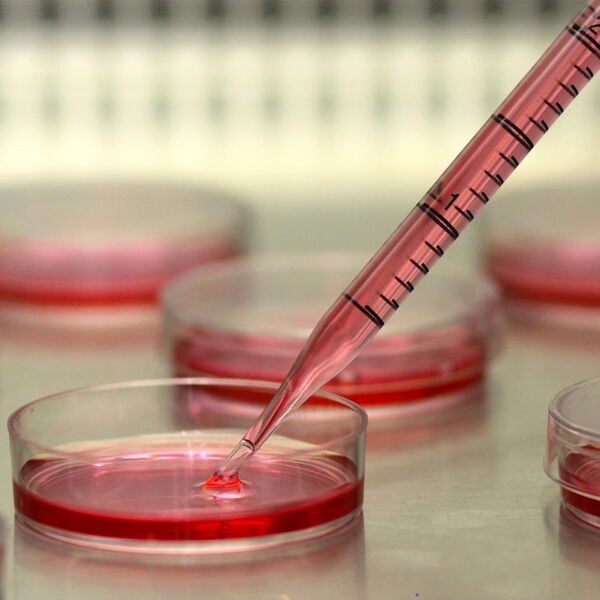
Serolojik Pipet 5ml - Steril Tek Kullanımlık 50Adet/Paket

Serolojik Pipet 5ml - Steril Tek Kullanımlık 50Adet/Paket
Serolojik Pipet 5ml - Steril Tek Kullanımlık 50Adet/Paket - Plastik Pipet - Pipet Çeşitleri - 50 adet/paket - Tek Tek Poşetli - Pipet Fiyatları
Ürün Kodu:P11060.005X50 - Taksimat:1/10ml - Sıfır Ürün - Steril Pipet - Taksimatlı Pipet - Tek Kullanımlık, Pyrogen, Dnase Rnase Free - Ekstra Hacim için Negatif Gösterge
Serolojik Pipet 5ml - Steril Tek Kullanımlık 50Adet/Paket - Her Hacim İçin Farklı Renkte Baskı - Siyah Boyalı Gösterge - Taksimatlı Pipet - Tüm Hacimler Mevcuttur
Borox P11060 Sterile Serological Pipette - Colour-coded Plugs For Ease of Selection - Negative Scale Provides Certain Amount of Additional Sampling Capacity
- Esas olarak belirli hacimdeki sıvı numuneler için doğru ölçüm veya transfer için kullanılır
- Hücre kültürü, bakteriyoloji, klinik araştırma vb. alanlarda yaygın olarak kullanılır.
- 6 kapasitede mevcuttur: 1,0ml, 2,0ml, 5,0ml, 10,0ml, 25,0ml, 50,0ml
- Net ve basit derecelendirme ve ayrıca ekstra hacim için negatif gösterge, sıvı çizimi ve okumayı kolaylaştırır.
- Mükemmel çift taraflı derecelendirme tasarımı, sıvı ekleme veya azaltma talebini ideal olarak karşılar.
- Pipet hacimlerinin kolay tanımlanması için hepsi için ayrı renk kodlaması mevcuttur
- Tüm serolojik pipetler yüksek kaliteli filtrelerle birleştirilmiştir.
|
Ürün Kodu |
Hacim (ml) |
Uzunluk(mm) |
Ambalaj |
|
P11060.001 |
1 |
270 |
100 Adet/Paket |
|
P11060.002 |
2 |
273 |
100 Adet/Paket |
|
P11060.005 |
5 |
340 |
50 Adet/Paket |
|
P11060.010 |
10 |
345 |
50 Adet/Paket |
|
P11060.025 |
25 |
340 |
50 Adet/Paket |
|
P11060.050 |
50 |
370 |
25 Adet/Paket |